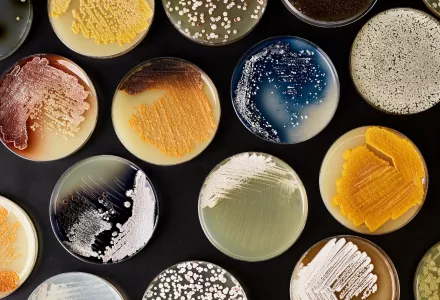
Petri dishes containing Streptomyces, an antibiotic-producing genus.

Executive Summary
Private funding of Research & Development (R&D) is crucial for sustaining Boston’s tech hub. Investments from businesses, Venture Capital firms, or philanthropic organizations may increase research and innovation, lead to more conversion of basic research to commercial applications, improve supply chains, and support talent development. While Federal funding for R&D is mainly focused on basic research, private funding is often aimed at more advanced stages of research, when a new product or service has already proven its commercial potential. In the U.S, the business or the private sector performs and funds most R&D activities.
Existing and emerging tech hubs are competing to attract private funding. While Boston’s tech hub is still an attractive hub for private investors, there are indications that Boston-based entrepreneurs and companies are lagging behind other tech hubs when it comes to attracting private funding. In 2018, Business R&D investments in Boston reached close to $30 Billion – a 25% increase in three years. However, this growth rate lags behind several other tech hubs, such as Seattle, the Bay Area, Detroit, and New York City. Compared to New York City, Boston-based entrepreneurs had access to fewer private investors, including a smaller number of locally-based investors. The scarcity of investors is felt across fields, including biotech (i.e. Boston’s strength), and affects every stage of the development pipeline. Furthermore, the pandemic has accelerated the growth of alternative tech hubs, including Michigan, North Carolina, and Colorado. While still small, these emerging hubs gradually attract higher volumes of Venture Capital Investments out of traditional tech hubs, such as Boston.
Local government and other stakeholders may adopt a range of policy tools to better position Boston’s tech hub in the national competition for private funding. Traditional tools, such as wider tax credits for R&D, grants or loans to startups, may be helpful but limited in their reach and efficiency. Other tools should try to make Boston more affordable and attractive for talent, and support scientists and potential entrepreneurs in their effort to commercialize their ideas and scientific breakthroughs.
Felber, Sarith, Chuck Meire, Gopal Nadadur and Ariel Higuchi. “Tech Hub Competition and Private Funding of the Innovation Life Cycle.” Belfer Center for Science and International Affairs, Harvard Kennedy School, June 2022